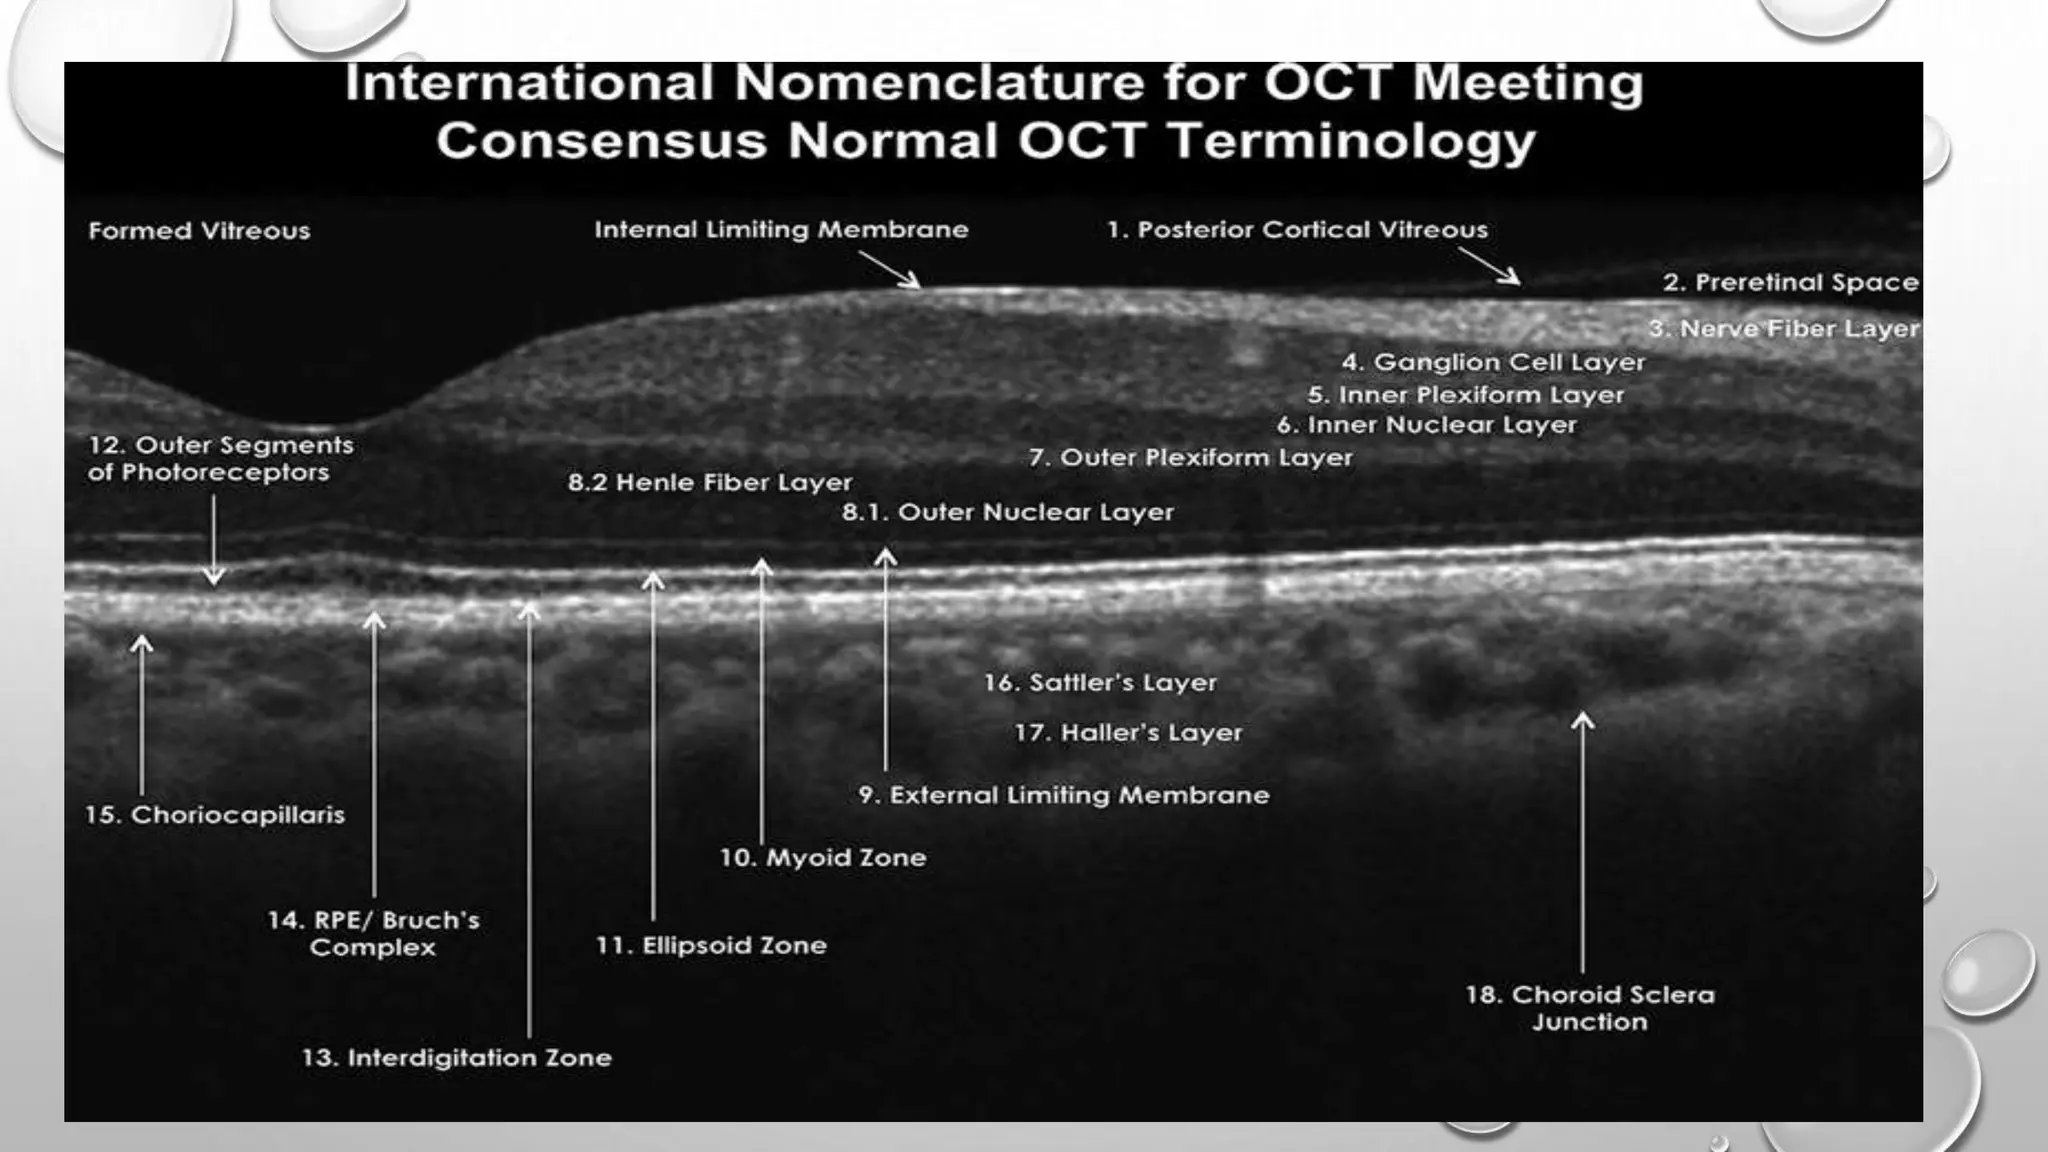

This document provides background information on optical coherence tomography (OCT) and its use in evaluating multiple sclerosis (MS). It discusses how OCT can be used to measure retinal nerve fiber layer thickness and ganglion cell layer thickness, which decrease over time in MS due to neuroaxonal damage and loss. Measuring these layers with OCT provides a sensitive method to track neurodegeneration in MS. It then describes the normal anatomy and layers of the retina in detail and how each layer appears on OCT scans. Finally, it discusses specific findings regarding retinal nerve fiber layer thinning observed in MS and how this correlates with visual function and other disease markers.



![• Optical coherence tomography (OCT) is a is a novel technique similar to ultrasound,
although using a light source “ near-infrared light.” Rather than an acoustic source, to take
cross-section pictures of the retina. With OCT, each of the retina’s distinctive layers can be
seen, allowing to map and measure their thickness.
• OCT is inexpensive, reproducible, well tolerated, fast, painless, and easily repeatable.
• The first commercially available OCT 1991 (OCT 1, humphrey instruments, inc.) Provided
an axial resolution of 15 μm in tissue, (time domain OCT [TD-OCT]), more recent OCT
devices are capable of acquiring scans with an axial resolution of up to 2 μm in tissue,
frequency domain OCT (FD-OCT) or spectral domain OCT (SD-OCT).
BACKGROUNG “CONT.”](https://image.slidesharecdn.com/opticalcoherencetomographyinmultiplesclerosis-170319233500/75/Optical-coherence-tomography-in-multiple-sclerosis-4-2048.jpg)